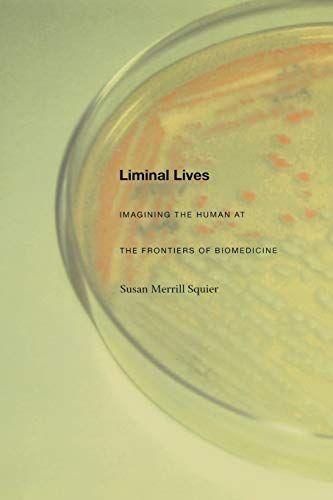

Liminal Lives Imagining the Human at the Frontiers of Biomedicine
Embryo adoptions, stem cells capable of transforming into any cell in the human body, intra- and inter-species organ transplantation—these and other biomedical advances have unsettled ideas of what it means to be human, of when life begins and ends. In the first study to consider the cultural impact of the medical transformation of the entire human life span, Susan Merrill Squier argues that fiction—particularly science fiction—serves as a space where worries about ethically and socially charged scientific procedures are worked through. Indeed, she demonstrates that in many instances fiction has anticipated and paved the way for far-reaching biomedical changes. Squier uses the anthropological concept of liminality—the state of being on the threshold of change, no longer one thing yet not quite another—to explore how, from the early twentieth century forward, fiction and science together have altered not only the concept of the human being but the contours of human life. Drawing on archival materials of twentieth-century biology; little-known works of fiction and science fiction; and twentieth- and twenty-first century U.S. and U.K. government reports by the National Institutes of Health, the Parliamentary Advisory Group on the Ethics of Xenotransplantation, and the President’s Council on Bioethics, she examines a number of biomedical changes as each was portrayed by scientists, social scientists, and authors of fiction and poetry. Among the scientific developments she considers are the cultured cell, the hybrid embryo, the engineered intrauterine fetus, the child treated with human growth hormone, the process of organ transplantation, and the elderly person rejuvenated by hormone replacement therapy or other artificial means. Squier shows that in the midst of new phenomena such as these, literature helps us imagine new ways of living. It allows us to reflect on the possibilities and perils of our liminal lives.